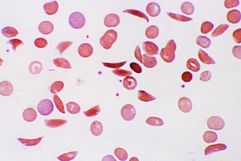

هل تتورم أصابعك؟ إليك 15 سبباً محتملاً

▪ واتس المملكة:
.
يُعاني كثير من الناس من تورم بعض أعضاء الجسم، إلا أن تورم الأصابع له طبيعة خاصة، نظراً لأهمية اليدين والقدمين في حياتنا، كما أن تورم الأصابع يعد عرضاً لبعض الأمراض الخطيرة. تتنوع أسباب تورم الأصابع حسب الحالات المرضية، نستعرض هنا 15 سبباً محتملاً له.
1- احتباس السوائل: يحدث تورم الأصابع عندما تتجمع سوائل الجسم في الأنسجة أو المفاصل، حتى إنك قد لا تستطيع أن تلبس خاتمك. قد يكون السبب زيادة الملح في وجباتك، وهذا لا يدعو عادة للقلق، لكن أحياناً قد يكون سبب تورم اليدين مشكلة صحية تحتاج إلى علاج.

2- التمارين والحرارة: يحتاج قلبك ورئتاك وعضلاتك إلى أكسجين عند ممارسة التمارين، لذا يتجه كثير من الدم إليها ويقل الدم المتدفق إلى يديك، فتتفاعل الأوعية الدموية الصغيرة مع هذا الانخفاض للدم، ما يجعل أصابعك تنتفخ. وبالمثل عندما ترتفع حرارة جسمك في الطقس الحار، ولحدوث التبريد تنتفخ الأوعية الدموية في جلدك فتنخفض الحرارة، وهذا طبيعي جداً.

3- الإصابات: يحدث التورم أيضاً في حال حدوث تمزق في الأربطة أو التواء في أحد أصابعك، أو الوتر أو خلع أو حتى كسر في العظام. إذا كانت الإصابة بسيطة فقد يكون علاج الألم هو الثلج والراحة فقط، وإلا فعليك مراجعة طبيبك، خاصة لو أصبت بالحمى أو أصبح الألم غير محتمل.

4- العدوى: ثلاث حالات تسبب تورماً للأصابع وهي عدوى الهربس بتقرحات دموية صغيرة ومنتفخة، والداحس وهو التهاب في قاعدة الظفر نتيجة بكتيريا أو فطريات، أو الالتهاب الصديدي. يمكن أن تنتشر الالتهابات في الأصابع أو أجزاء أخرى من الجسم إذا لم يتم علاجها مبكراً.

5- التهاب المفاصل:يؤثر التهاب المفاصل الروماتويدي على محيط المفاصل مسبباً تورماً وألماً وتصلباً بها، وتظهر الأعراض أولاً في مفاصل اليدين غالباً. ويؤثر التهاب المفاصل الصدفي على المصابين بالصدفية، حيث تتورم أصابع اليدين والقدمين بشدة. وكلا النوعين من التهاب المفاصل خطيران وقد يتسببان في تلف المفاصل ومشاكل أخرى للجسم.

6- النقرس: يصيب النقرس أو “مرض الأغنياء” محبي تناول الكثير من اللحوم والمأكولات البحرية، مسبباً ألماً شديداً وتورماً، عادة في الإصبع الكبير للقدم، وقد يصيب أي مفصل بما فيها أصابع اليد. يصاب المريض بالنقرس عندما ترتفع في دمه نسبة حمض “اليوريك” ليتحول إلى بلورات تتجمع على المفاصل.

7- تناول الأدوية: بعض الأدوية تسبب ألم المفاصل ومنها الأدوية الشائعة مثل الأسبرين وغيره، والمنشطات، وبعض أدوية السكري، ارتفاع ضغط الدم، أدوية الأعصاب، العلاجات الهرمونية مثل الإستروجين أو التستوستيرون، فلا داعي للقلق إذا كنت تتناول تلك الأدوية.

8- متلازمة “النفق الرسغي”: هناك عصب منتشر في المعصم يسمى النفق الرسغي، ويشكو البعض من أن أصابعهم تصبح عديمة الفائدة ومنتفخة، وقد تؤلمهم أو يشعرون بالوخز أو الخدر أيضاً. تكرار نفس حركة اليد في عمل أو غيره مراراً يمكن أن يسبب هذه المتلازمة، وهي قابلة للعلاج ولا تحدث أضراراً دائمة.

9- صوت الأصابع: إذا سمعت صوت إصبعك عند ثنيه أو فرده، فقد يكون هناك انتفاخ أو تورم حول الوتر، وأحياناً يحدث ذلك بعد الجراحة لمتلازمة النفق الرسغي. صدور صوت للأصابع، يعد أكثر شيوعاً لدى المصابين بالتهاب المفاصل الروماتويدي أو السكري.

10- مرضى الكلى: تخلص الكليتان الجسم من النفايات والسوائل الزائدة، وإحدى العلامات الأولى التي تشير إلى وجود مشكلة في الكلى هي انتفاخ أصابعك وقدميك وحول عينيك. على الأرجح طبياً أن تصاب بمرض كلوي إذا كنت تعاني من مرض السكري أو ارتفاع ضغط الدم. عليك التحكم في هذه الأمراض لحماية كليتيك، وإلا ستكون العواقب وخيمة.

11- الحمل: في حالة الحمل، يتوقع تورم الأصابع والكاحلين والقدمين، غير أن التورم المفاجئ، وخاصة في اليدين والوجه، يمكن أن يكون علامة على تسمم الحمل، بارتفاع ضغط الدم بشكل خطير. التسمم هنا يؤثر على الكلى، فيحدث التورم نتيجة خلل معالجة السوائل، وقد يصاحبه صداع شديد وألم في البطن ومشاكل في الرؤية.

12- مرض فقر الدم المنجلي: خلايا الدم الحمراء الطبيعية تبدو مرنة، وعند الإصابة بهذا المرض تتحول الخلايا إلى قاسية فتتعثر في الأوعية الدموية الصغيرة وتمنع تدفق الدم في اليدين والقدمين، ما يسبب التورم المؤلم، وقد يسبب أيضاً التهابات وفقر الدم والسكتة الدماغية والعمى.
13- التهاب الغدد الليمفاوية: يحدث التورم عندما لا يتم تصريف السوائل في الغدد اللمفاوية جيداً، ويكون ذلك أحياناً عَرَضاً جانبياً لعلاجات السرطان. يتم إزالة الغدد الليمفاوية تحت الإبطين عند النساء المصابات بسرطان الثدي غالباً للتحقق من وجود السرطان،ما يؤدي إلى حدوث تورم في الذراعين واليدين.

14- مرض “رينود”: مشكلة نادرة تصيب الأوعية الدموية في أصابعك وأصابع قدميك، فتؤدي بهم إلى الانكماش وهي باردة، كما أن نقص تدفق الدم يجعل أصابعك باردة ومؤلمة، وقد تتحول إلى اللون الأبيض أو الأزرق. عندما تتسع الأوعية ويعود لها تدفق الدم، قد يحدث أن تتضخم أصابعك وتنتفخ. في الحالات الخطيرة قد يؤدي نقص تدفق الدم إلى حدوث تقرحات أو موت الأنسجة.

15- تصلب الجلد: هو مرض يصيب الجهاز المناعي ويخدع الجسم فيعامل البروتين على أنه كولاجين، ما يسبب تصلباً للبشرة، وقد يؤثر على باقي أعضاء الجسم أيضاً، فتصبح يداك جامدتين قاسيتين، وتنتفخ أصابعك مثل النقانق. البعض تكون أعراضه خفيفة، وحالات أخرى تكون أكثر خطورة..، وهو مرض لا يختفي ولكن يمكن التخفيف منه بعلاجه.
